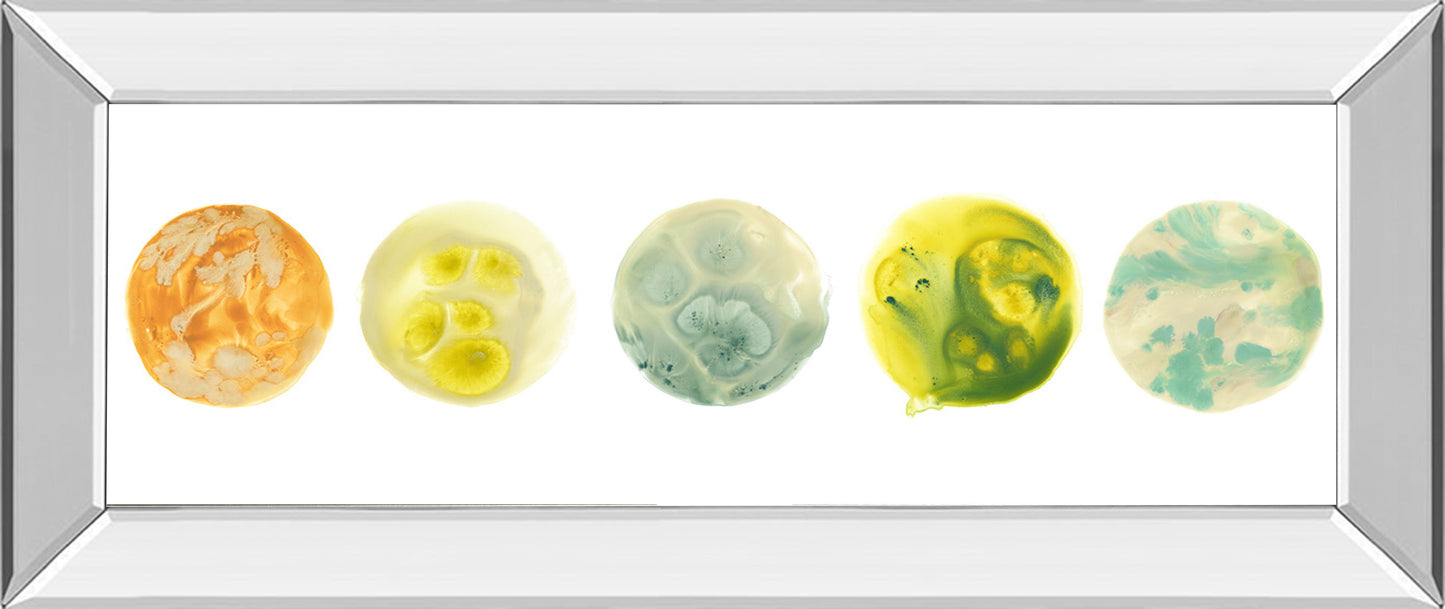

1
/
of
3
SKU:1916MF
Classy Living
Panetary VIII By June Erica Vess - Mirror Framed Print Wall Art - Yellow
Panetary VIII By June Erica Vess - Mirror Framed Print Wall Art - Yellow
Regular price
$149.99 USD
Regular price
$209.99 USD
Sale price
$149.99 USD
Shipping calculated at checkout.
Quantity
Couldn't load pickup availability
Celestial Orbs invites you to explore a serene cosmic landscape through five abstract planetary forms, each rendered in gentle swirls of orange, yellow, green, and blue. Set against a crisp white background, these orbs evoke a sense of calm and wonder, as if glimpsing distant worlds through a dreamlike lens. Encased in a sleek mirrored frame, the artwork reflects ambient light to brighten any living room, office, or bedroom, adding depth and sophistication to your space. Crafted with premium real glass and ready to hang, this piece blends contemporary artistry with expert craftsmanship, making it a refined addition to modern interiors.
Product Features
Panetary VIII By June Erica Vess - Mirror Framed Print Wall Art - Yellow
42.0"W x 3.0"D x 18.0"H - 15.0 lb
Product Features
- Sleek 2.5-Inch Mirrored Frame - A modern reflective frame that adds depth, elegance, and a touch of luxury to any space.
- Premium Real Glass - Crystal-clear glass protects artwork while enhancing color vibrancy and detail.
- Ready to Hang - Professionally assembled with durable hardware for effortless installation.
- Crafted in the USA - Proudly made with expert craftsmanship and premium materials.
- Social Impact - A meal is donated to a hungry American child with the purchase of this piece of classy art.
- Abstract
- Style: Graphic Art
- Collection: Classy Living - 18X42 Mirror Frame Print
- Horizontal
- June Erica Vess
- Wipe clean with dry, soft cloth.
- 1 Year Limited Manufacturer
Panetary VIII By June Erica Vess - Mirror Framed Print Wall Art - Yellow
42.0"W x 3.0"D x 18.0"H - 15.0 lb
Share